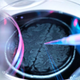

Raziskovalni dosežek, s katerim so se končala desetletja neuspešnih raziskav

Zgodovinska najdba oz. prvo zdravilo, ki upočasni razkroj možganskih celic pri najpogostejši obliki demence – Alzheimerjevi bolezni. Fotografija je simbolična. Eksperimentalno zdravilo z imenom lacanemab, je zdravilo za Alzheimerjevo bolezen …
![]() Maribor24 · 3L
Maribor24 · 3L
Velikanski preboj v zdravljenju Alzheimerjeve bolezni
Ne gre za čudežno zdravilo, a je prvo, ki spremeni potek bolezni. Po desetletjih neuspehov je pred nami očitno nova doba zdravil, s katerimi bo mogoče zdraviti Alzheimerjevo bolezen, najpogostejšo …
![]() Svet24 · 3L
Svet24 · 3L
Odkrili zdravilo proti Alzheimerjevi bolezni - ali pač?

vir: BBC BBC - Farmacevtski podjetji Biogen in Eisai sta odkrili prvo zdravilo, ki upočasni napredovanje Alzheimerjeve bolezni, je novica dneva, o kateri poročajo BBC , The New York Times …
SloTech · 3L
Znanstveniki iznašli novo zdravilo za Alzheimerjevo bolezen

Popolni rezultati napredne klinične študije (faze III), ki so jo izvedli na skoraj 1800 osebah , ki so jih spremljali 18 mesecev, so potrdili 27-odstotno zmanjšanje upadanja kognitivnih sposobnosti pri …
 Koroške novice · 3L
Koroške novice · 3L
Novo zdravilo za Alzheimerjevo bolezen

Novo zdravilo lecanemab se je izkazalo kot učinkovito pri upočasnitvi upadanja kognitivnih sposobnosti pri bolnikih z Alzheimerjevo boleznijo Znanstveniki so danes pozdravili podrobne rezultate klinične študije novega zdravila lecanemab, ki …
Mladina · 3L
Znanstveniki novo zdravilo za Alzheimerjevo bolezen pozdravili kot pomemben preboj

Znanstveniki so danes pozdravili podrobne rezultate klinične študije novega zdravila lecanemab, ki se je izkazalo kot učinkovito pri upočasnitvi upadanja kognitivnih sposobnosti pri bolnikih z Alzheimerjevo boleznijo. Opozarjajo sicer, da …
![]() Primorske novice · 3L
Primorske novice · 3L
Znanstveniki zdravilo za Alzheimerjevo bolezen pozdravili kot velik preboj

Zdravilo se je izkazalo kot učinkovito pri upočasnitvi upadanja kognitivnih sposobnosti. Opozarjajo, da je mogoče manjše izboljšanje in hudi stranski učinki. Znanstveniki so danes pozdravili podrobne rezultate klinične študije novega …
![]() Delo · 3L
Delo · 3L
Zgodovinski preboj, "smo priča začetku zdravljenja Alzheimerjeve bolezni"

Zdravilo omogoča le majhno izboljšanje, v nekaterih primerih ima lahko tudi hude stranske učinke, a gre za velik preboj na področju zdravljenja Alzheimerjeve bolezni. Današnji podrobni rezultati klinične študije novega …
![]() Svet24 · 3L
Svet24 · 3L
Pomemben preboj: nove študije zdravilo za Alzheimerjevo bolezen

Znanstveniki so danes pozdravili podrobne rezultate klinične študije novega zdravila lecanemab, ki se je izkazalo kot učinkovito pri upočasnitvi upadanja kognitivnih sposobnosti pri bolnikih z Alzheimerjevo boleznijo. Opozarjajo sicer, da …
![]() Siol.net · 3L
Siol.net · 3L
Znanstvenikom je uspelo! Dosegli velik preboj pri boju proti zahrbtni bolezni

Z boleznijo, ki prizadene predvsem starejše, se bori 55 milijonov ljudi. V nekaj desetletjih pa se bo število obolelih po napovedih potrojilo. 👇 Znanstvenikom je uspel velik preboj pri boju …
![]() Metropolitan.si · 3L
Metropolitan.si · 3L
beta amoloidznanstvenikiprebojlacanemabdemencaraziskavabolezenalzheimerjeva bolezenstranski učinki
Zdravilo za Alzheimerjevo bolezen, ki je bilo razglašeno za pomemben preboj

Prvo zdravilo za upočasnitev uničenja možganov pri Alzheimerjevi bolezni je bilo razglašeno za izjemen pomemben dosežek. Poglejmo si, zakaj. Preboj v naslednji raziskavi končuje desetletja neuspeha in kaže, da je …
![]() Vizita.si · 3L
Vizita.si · 3L
zdraviloalzheimerjeva bolezenstarostne bolezendemencaobetavna študija
Preboj pri zdravljenju Alzheimerjeve bolezni? Lecanemab naj bi upočasnil napredovanje.

Eksperimentalno zdravilo za Alzheimerjevo bolezen podjetij Eisai in Biogen z imenom lecanemab je v klinični raziskavi doseglo dobre rezultate pri upočasnjevanju kognitivnega upada, vendar so nekateri bolniki imeli tudi resne …
![]() RTV Slovenija · 3L
RTV Slovenija · 3L
'Zmagoslavni preboj': prvo zdravilo za Alzheimerjevo bolezen

Po desetletju neuspešnih raziskav je znanstvenikom uspel preboj. Ustvarili so prvo zdravilo, ki upočasni razkroj možganskih celic pri najpogostejši obliki demence - Alzheimerjevi bolezni. Strokovnjaki najdbo označujejo za zgodovinsko. Zdravilo …
![]() 24ur · 3L
24ur · 3L
Z obiskom in uporabo spletnega mesta soglašate s piškotki.